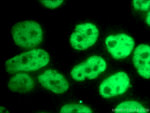
CREST Antibody in Immunocytochemistry (ICC/IF)

Search
Proteintech
CREST Polyclonal Antibody
{{$productOrderCtrl.translations['antibody.pdp.commerceCard.promotion.promotions']}}
{{$productOrderCtrl.translations['antibody.pdp.commerceCard.promotion.viewpromo']}}
{{$productOrderCtrl.translations['antibody.pdp.commerceCard.promotion.promocode']}}: {{promo.promoCode}} {{promo.promoTitle}} {{promo.promoDescription}}. {{$productOrderCtrl.translations['antibody.pdp.commerceCard.promotion.learnmore']}}
产品信息
12439-1-AP
种属反应
已发表种属
宿主/亚型
分类
类型
抗原
偶联物
形式
浓度
规格
纯化类型
保存液
内含物
保存条件
运输条件
产品详细信息
Immunogen sequence: CTQYQQILH RNLVYLATIA DSNQNMQSLL PAPPTQNMNL GPGALTQSGS SQGLHSQGSL SDAISTGLPP SSLLQGQIGN GPSHVSMQQT APNTLPTTSM SISGPGYSHA GPASQGVPMQ GQGTIGNYVS RTNINMQSNP VSMIQQQAAT SHYSSAQGGS QHYQGQSSIA MMGQGSQGSS MMGQRPMAPY RPSQQGSSQQ YLGQEEYYGE QYSHSQGAAE PMGQQYYPDG HGDYAYQQSS YTEQSYDRSF EESTQHYYEG GNSQYSQQQA GYQQGAAQQQ TYSQQQYPSQ QSYPGQQQGY GSAQGAPSQY PGYQQGQGQQ YGSYRAPQTA PSAQQQRPYG YEQGQYGNYQ Q (47-396 aa encoded by BC034494)
靶标信息
Synovial sarcomas occur most frequently in the extremities around large joints. More than 90% of cases have a recurrent and specific chromosomal translocation, t(X;18)(p11.2;q11.2), in which the 5-prime end of the SS18 gene (MIM 600192) is fused in-frame to the 3-prime end of the SSX1 (MIM 312820), SSX2 (MIM 300192), or SSX4 (MIM 300326) gene. The SS18L1 gene is homologous to SS18.
仅用于科研。不用于诊断过程。未经明确授权不得转售。
生物信息学
蛋白别名: Calcium-responsive transactivator; Calcium-responsive transcription coactivator; SS18-like protein 1; SS18L1, nBAF chromatin remodeling complex subunit; synovial sarcoma translocation gene on chromosome 18-like 1; SYT homolog 1; unnamed protein product
基因别名: A230053O16Rik; CREST; KIAA0693; LP2261; SMARCL2; SS18L1
UniProt ID: (Human) O75177, (Mouse) Q8BW22, (Rat) Q91XJ0
Entrez Gene ID: (Human) 26039, (Mouse) 269397, (Rat) 192352